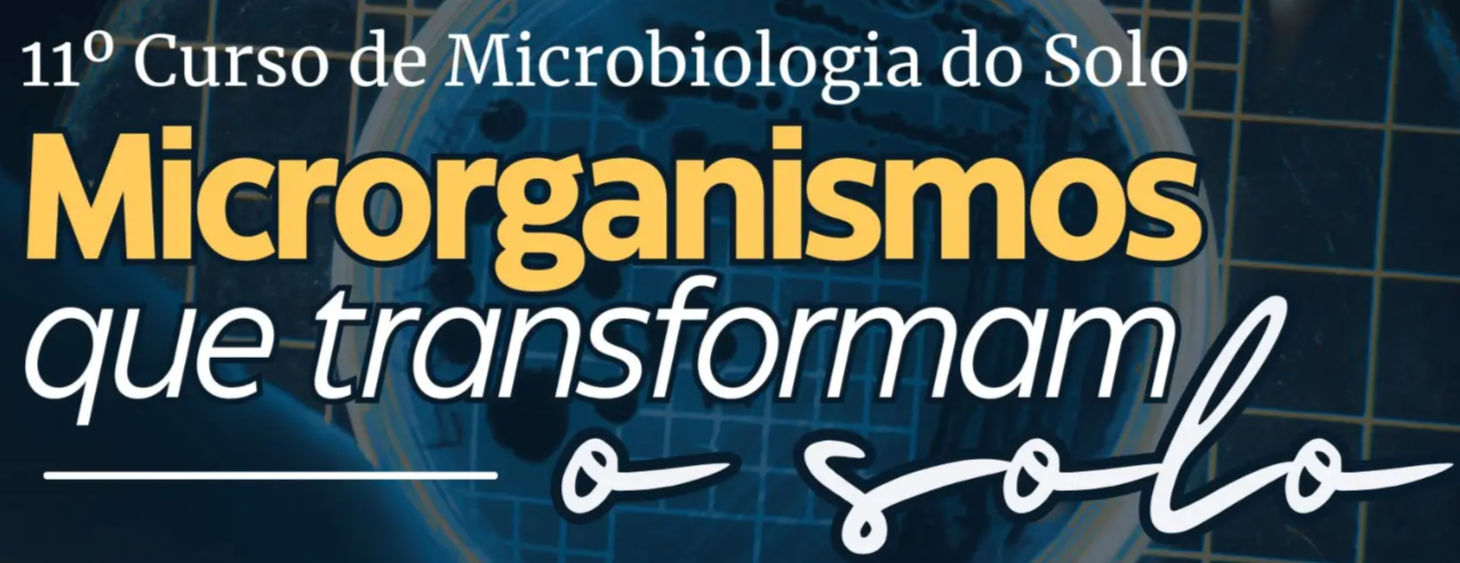

A opinião de quem participou dos nossos cursos

O solo é vivo!
E quem entende isso, sai na frente.
9 e 10 de junho de 2026 | Piracicaba – SP






9 e 10 de junho de 2026,
das 8h às 18h15
Em Piracicaba–SP, a apenas 150 km da capital,
no Parque Tecnológico de Piracicaba.
R. Cezira Giovanoni Moretti, 600 Jardim - Santa Rosa, Piracicaba
.
VERSÃO ON-LINE: O curso também terá versão on-line, transmitida simultaneamente, para que você possa participar de qualquer lugar do mundo.
Vagas limitadas
INSCREVA-SE AGORA
A opinião de quem participou dos nossos cursos
FABIO VANIN CLAUDINO
"Um dos pontos fortes do curso é o estudo científico que vem da Universidade aplicado no nosso negócio que é no campo, ajudando o produtor com novas tecnologias que estão vindo."
DAINE FRANGIOSI
"O trabalho bem feito da Andrios em consultorias e em eventos em nível nacional, tem trazido cada vez mais profissionais para fazer esse curso".
DANIELLE GOMES
"Me surpreendeu a qualidade dos palestrantes e dos temas abordados. Foi uma imersão dentro do assunto microbiologia e bioinsumos."
CAIO PIMENTA JUNQUEIRA
"Entender de microorganismo de solo é resposta direta em produtividade"
MANECO ZAGO
"A Andrios é pioneira no assunto quando a gente fala de microbiologia. É um assunto que a gente vem sempre tentando levar pro agricultor há muito muitos anos e aqui a gente encontra muita tecnologia, pessoal especializado e inovações.
LETÍCIA FERNANDA LAVEZZO
“A estrutura do evento e toda a organização tá incrível. Andrios mais uma vez pensou em cada detalhe para que a gente nesses três dias se sentisse acolhido.”
JÉSSICA ANDRADE
“Sou do Sul de Minas, trabalho em Três Pontas, numa empresa de fertilizante organomineral. Eu comecei a fazer o curso da Andrios em 2020, 2021, 22. Ano passado eu fiz o online e o e o presencial. Esse ano estou de volta!”
GRACYELLE GONÇALVES
“É evento muito importante para nós do agronegócio, traz muita estratégia de manejo. Mais ferramentas para a gente agir no campo.”
Habitantes nativos do solo e essenciais para as plantas
8h30 Abertura: Cristiane e Fernando Andreote
9h00 A microbiologia no contexto da saúde do solo: Fernando Andreote (ESALQ/USP)
10h00 Intervalo
10h30 O microbioma do solo: como a ecologia microbiana impacta a produtividade: Rodrigo Mendes (Embrapa)
11h30 Palestra tecnológica
11h45 Discussão: Palestrantes e Fernando Andreote
12h10 Almoço
Expandindo as fronteiras do conhecimento
13h40 Solos supressivos: inovações para a agricultura sustentável: Francisco Dini Andreote (The Pennsylvania State University - EUA)
14h35 Compostos orgânicos voláteis como bioativos: Viviane Cordovez (NIOO-KNAW - Holanda)
15h30 Palestra tecnológica
15h45 Intervalo
16h15 Manipulação genômica em microrganismos: Maria Carolina Quecine Verdi (ESALQ/USP)
17h15 Palestra tecnológica
17h30 Discussão: Palestrantes e Fernando Andreote
Funções microbianas de interesse agronômico
8h00 Sequenciamento genético na agricultura: para que serve e quando usar princípios de doenças fúngicas e estratégias de controle: Rodrigo Mendes (Embrapa)
9h00 Prospecção microbiana para a agricultura: Itamar Soares de Melo (Embrapa)
10h00 Palestra tecnológica
10h15 Intervalo
10h45 Mecanismos de ação dos biodefensivos: Fernando Andreote (ESALQ/USP)
11h35 Discussão: Palestrantes e Fernando Andreote
12h00 Almoço
Da teoria para a prática
13h40 Manejo de pragas e doenças com o uso de bioinsumos: Erich dos Reis Duarte (Universidade Bandeirantes do Paraná)
14h40 Mercado de Bioinsumos no Brasil e no mundo: Patrocinadores Diamante e Fernando Andreote
15h30 Palestra tecnológica
15h45 Intervalo
16h15 Construindo manejos da microbiologia na agricultura: Fernando Andreote (ESALQ/USP)
17h15 Palestra tecnológica
17h30 Discussão: Palestrantes e Fernando Andreote
Palestrantes confirmados
Aprenda com renomados pesquisadores e profissionais do mercado e transforme sua produção agrícola!

FERNANDO ANDREOTE
Engenheiro Agrônomo pela ESALQ/USP, Doutor em Genética e Melhoramento de Plantas pela ESALQ/USP, com experiência nas Universidades de Wageninen e Groningen, na Holanda. Tem Pós-doutorado na Embrapa Meio Ambiente e atualmente é Professor Titular em Microbiologia do Solo na ESALQ/USP.

RODRIGO MENDES
Engenheiro Agrônomo e Doutor em Genética e Melhoramento de Plantas pela ESALQ/USP e Pós-doutorado na Universidade de Wageningen e na Universidade da Califórnia Berkeley. Atualmente exerce a função de pesquisador na Embrapa Meio Ambiente na área de microbioma de plantas e rizosfera e também é professor no Programa de Pós-Graduação em Microbiologia Agrícola da Universidade de São Paulo.

FRANCISCO ANDREOTE
Engenheiro Agrônomo e Mestre em Genética e Melhoramento de Plantas pela ESALQ/USP. Possui PhD em Ecologia Microbiana pela Universidade de Groningen (Holanda) e Pós-Doutorado na Universidade de Groningen e no Instituto de Ecologia da Holanda. Atualmente é Professor Associado na Penn State University (EUA) e afiliado ao One Health Microbiome Center (PSU, EUA).

VIVIANE CORDOVEZ
Bacharel em Ciências Biológicas pela UEM, Mestre e Doutora em Ecologia Microbiana pela Universidade de Wageningen (Holanda). Possui pós-doutorado pela Universidade de Leiden e pelo Instituto Holandês de Ecologia (NIOO-KNAW), onde atualmente é Líder de Grupo de Pesquisa em interações planta-microbioma.

MARIA CAROLINA QUECINE VERDI
Engenheira Agrônoma e Doutora em Genética e Melhoramento de Plantas pela ESALQ/USP, com período sanduíche na Oregon State University (EUA). É membro afiliada da Academia Brasileira de Ciências e, atualmente, Professora Doutora em Genética Molecular e Coordenadora de Pós-Graduação na ESALQ/USP.

ITAMAR SOARES DE MELO
Engenheiro Agrônomo pela UFAL, Mestre e Doutor em Genética pela ESALQ/USP, com pós-doutorados na London University (Reino Unido). É Pesquisador da Embrapa Meio Ambiente e docente na USP, atuando como Curador da Coleção de Microrganismos de Importância Agrícola.

ERICH DOS REIS DUARTE
Graduado em Administração, Direito, Agronomia e Biomedicina com Mestrado em Agronomia pela UENP. Possui Doutorado pela Universidade Nacional da Argentina (UCES) com foco em Bioinsumos na Agricultura. Sua trajetória destaca-se pela formação multidisciplinar aplicada ao setor agroambiental.
CURSO PRESENCIAL
1º LOTE
12x de R$ 124,11 ou R$ 1.199,99 à vista
VERSÃO ON-LINE
(com transmissão simultânea)
1º LOTE
12x de R$ 67,22 ou R$ 650,00 à vista

Acesso completo à programação

Espaço para discussão e visita técnica à Andrios

Almoços e coffee breaks (na versão presencial)

Certificado de conclusão do curso

Conheça a Andrios
A Andrios não é apenas uma empresa. Somos um time de especialistas motivados a difundir o uso da microbiologia do solo para aprimorar seu trabalho na agricultura.
Quando começamos, em 2016, sabíamos que com a microbiologia do solo era possível ter uma agricultura mais sustentável tanto para o agricultor como para o meio ambiente.
E hoje podemos dizer que estamos no caminho certo, levado a agricultura a novos patamares de produtividade, gerando alimentos, energia e produtos mais sustentáveis. Unindo pesquisa, ensino e prática com vantagens tecnológicas.
Como?
Estamos aqui para elevar a agricultura a novos patamares de produtividade, gerando alimentos, energia e produtos mais sustentáveis.
Com essas iniciativas, a Andrios reafirma seu papel como referência em ações educacionais na microbiologia do solo.

Qual é o foco principal do curso de Microbiologia do Solo?
O curso visa aprofundar o entendimento sobre a microbiologia do solo e suas aplicações na agricultura. Exploraremos estratégias inovadoras para potencializar a produtividade e sustentabilidade na agricultura.
O curso oferece certificado de conclusão?
Sim, todos os participantes, tanto presenciais quanto on-line, receberão certificado de conclusão ao final do curso, atestando sua participação nas 16 horas de aprendizado.
Como será a modalidade on-line do curso?
A versão on-line será transmitida simultaneamente ao evento presencial. Os participantes on-line terão acesso a todas as palestras e receberão o mesmo certificado de conclusão.
As palestras do curso ficarão gravadas para acesso posterior dos participantes on-line?
Não, as palestras não ficarão gravadas. Recomendamos que os participantes on-line estejam presentes durante as transmissões ao vivo para aproveitar ao máximo as interações, perguntas e respostas, proporcionando uma experiência completa e enriquecedora.
Como serão distribuídas as 16 horas de aulas durante os dois dias?
O curso será dividido em 4 painéis temáticos ao longo dos dois dias, totalizando 16 horas de aulas transformadoras. Na modalidade do curso presencial, cada dia incluirá intervalos para coffee breaks e almoço, proporcionando momentos de networking e discussões informais.
Há benefícios inclusos na inscrição, como alimentação, por exemplo?
Os participantes presenciais terão acesso a almoços e coffee breaks durante os dias do evento.
Como garantir minha vaga e qual é a política de reembolso?
Para garantir sua vaga, basta realizar a inscrição pelo nosso site. Quanto à política de reembolso, consulte os termos específicos disponíveis na área de inscrição do site.
Este curso é adequado para iniciantes na área?
O curso é projetado para atender a diversos níveis de conhecimento, desde iniciantes até profissionais experientes. As palestras abrangerão desde conceitos fundamentais até estratégias avançadas, proporcionando um aprendizado abrangente.
Como posso entrar em contato em caso de dúvidas adicionais?
Fique à vontade para entrar em contato por e-mail cursos@andriosassessoria.com.br ou acesse o WhatsApp aqui pela nossa página. Queremos ajudar e esclarecer todas as suas dúvidas.
Caso eu não possa estar presente no curso presencial após ter realizado minha inscrição com pagamento, posso designar outro participante pra vir no meu lugar?
Sim, é possível fazer a troca de participantes. A substituição de nomes pode ser realizada até 10 dias antes da data de início do curso.
Antonio's Palace Hotel
Av: Independência, 2.805
Tel: (19) 3417-6000
IBIS Styles
Rua Saldanha Marinho, 1.515
Tel: (19) 3373-3000
IBIS Piracicaba
Av. Armando Dedini, 125
Tel: (19) 2105-5200
IBIS Budget
Av. Armando Dedini, 125
Tel: (19) 3372-5150
Class Hotel
Av. Centenário, 152
Tel: (19) 3417-3550
Beira Rio
Rua Luiz de Queiroz, 51
Tel: (19) 3401-1000
Occitano
Rua Marcelo Vacchi, 100
Tel: (19) 3429-0029
Asa Hotel
Rua Voluntários de Piracicaba, 429
Tel: (19) 3432-3622

Ainda tem dúvidas? Fale com
nosso time de suporte
cursos@andriosassessoria.com.br
WhatsApp - +55 19 3423-9502
Desenvolvido por: Ibold Comunicação e Marketing